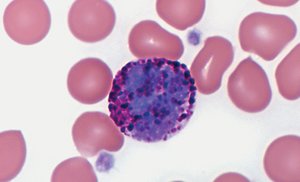
Basophil
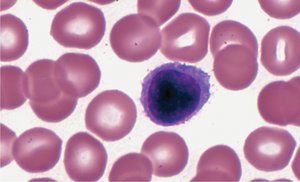
Lymphocyte
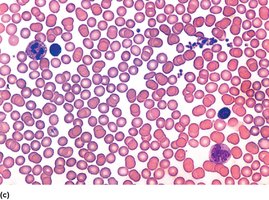
Non-agglutinated blood

BackChapter 12: Blood – Structure, Function, and Clinical Relevance
Study Guide - Smart Notes
Tailored notes based on your materials, expanded with key definitions, examples, and context.
Blood: Composition and Function
Introduction to Blood
Blood is a specialized connective tissue with a fluid matrix called plasma. It is essential for transporting substances throughout the body, maintaining homeostasis, and distributing heat. Blood, together with the heart and blood vessels, forms the circulatory system.
Key Components: Red blood cells (RBCs), white blood cells (WBCs), platelets, and plasma.
Formed Elements: RBCs, WBCs, and platelets produced in red bone marrow.
Main Functions: Transport of nutrients, oxygen, metabolic wastes, and carbon dioxide; defense against infection; stoppage of bleeding.

Blood Volume and Composition
Blood consists of plasma and formed elements. Plasma is a complex mixture, while formed elements are primarily RBCs.
Plasma: 55% of blood volume; contains water, proteins, nutrients, hormones, electrolytes, and wastes.
Formed Elements: 45% of blood volume; mainly RBCs (hematocrit), with WBCs and platelets making up less than 1%.
Normal Blood pH: 7.35–7.45.
Average Adult Blood Volume: ~5 liters.

Formed Elements of Blood
Red Blood Cells (Erythrocytes)
RBCs are biconcave disks, which increases their surface area for gas exchange and flexibility in blood vessels. They lack nuclei and most organelles, cannot reproduce, and contain hemoglobin for oxygen transport.
Shape: Biconcave, 7.5 μm diameter, 2.0 μm thick.
Hemoglobin: One-third of RBC content; binds oxygen (oxyhemoglobin – bright red) and releases it (deoxyhemoglobin – dark red).
Metabolism: Produce ATP by glycolysis; do not use transported oxygen.


Hemoglobin Structure
Hemoglobin is a protein composed of four globin chains and four heme groups, each containing iron. It is responsible for oxygen and some carbon dioxide transport.
Globin: Two alpha and two beta chains.
Heme: Contains iron, binds oxygen.

Red Blood Cell Production and Control
RBC production (erythropoiesis) occurs in red bone marrow after birth. It is regulated by erythropoietin, a hormone released in response to low oxygen levels.
Stem Cells: Hematopoietic stem cells (hemocytoblasts) differentiate into RBCs.
Life Span: ~120 days.
Regulation: Negative feedback via erythropoietin from kidneys and liver.
Polycythemia: Excess RBCs, causing viscous blood and oxygen deficiency.



Life Cycle and Breakdown of RBCs
RBCs are broken down by macrophages in the liver and spleen. Hemoglobin is split into heme and globin; heme is further degraded to iron and biliverdin, then bilirubin, which is excreted in bile.
Iron: Stored in liver or recycled.
Globin: Reused as amino acids.
Bilirubin: Excreted in bile or urine.

White Blood Cells (Leukocytes)
General Features
WBCs defend against disease, can leave the bloodstream (diapedesis), and move by amoeboid motion. They are produced in response to interleukins and colony-stimulating factors.
Types: Five types, distinguished by size, granularity, nucleus shape, and staining.
Diapedesis: Squeezing through vessel walls to reach tissues.
Positive Chemotaxis: Movement toward damaged tissues.

Types of White Blood Cells
Granulocytes: Contain granules, short life span (~12 hours).
Neutrophils: 50–70%; strong phagocytes.
Eosinophils: 1–3%; kill parasites, moderate inflammation.
Basophils: <1%; promote inflammation, secrete heparin and histamine.
Agranulocytes: No granules, longer life span.
Monocytes: 3–9%; largest, strong phagocytes, become macrophages.
Lymphocytes: 25–33%; smallest, responsible for immunity (B, T, NK cells).

Platelets (Thrombocytes)
Structure and Function
Platelets are cytoplasmic fragments of megakaryocytes, essential for hemostasis (stoppage of bleeding). They adhere to damaged vessel edges and form plugs.
Normal Count: 150,000–400,000/μL.
Life Span: ~10 days.
Thrombopoietin: Hormone regulating platelet production.
Thrombocytosis: High platelet count; Thrombocytopenia: Low platelet count, risk of bleeding.
Plasma
Composition and Functions
Plasma is the clear, straw-colored liquid part of blood, mostly water (92%), with proteins, nutrients, gases, electrolytes, and wastes.
Functions: Transport, regulation of fluid/electrolyte balance, pH maintenance.
Plasma Proteins: Albumins, globulins, fibrinogen (not used for energy).
Electrolytes: Sodium, potassium, calcium, magnesium, chloride, bicarbonate, phosphate, sulfate.
Nonprotein Nitrogenous Substances: Amino acids, urea, uric acid, creatine, creatinine.

Hemostasis
Mechanisms of Hemostasis
Hemostasis is the process of stopping bleeding after vessel injury. It involves three main steps: vascular spasm, platelet plug formation, and blood coagulation.
Vascular Spasm: Contraction of vessel wall muscle, lasts a few minutes.
Platelet Plug Formation: Platelets adhere to exposed collagen and each other, forming a plug.
Blood Coagulation: Series of reactions leading to fibrin formation and blood clot.



Blood Coagulation Process
Coagulation is the most effective means of hemostasis. Damaged tissues release tissue thromboplastin, activating a cascade that produces prothrombin activator, which converts prothrombin to thrombin. Thrombin then converts fibrinogen to fibrin, forming a clot.
Equation:
Equation:
Serum: Plasma minus clotting factors, remains after clot formation.
Positive Feedback: Clot formation promotes more clotting.
Clot Dissolution and Abnormal Clot Formation
Clots are dissolved by plasmin, which digests fibrin. Abnormal clots (thrombus, embolus) can cause serious conditions like coronary thrombosis, pulmonary embolism, and infarction. Atherosclerosis increases risk of abnormal clot formation.

Blood Groups and Transfusions
Antigens and Antibodies
Blood transfusions require compatibility testing for ABO and Rh blood groups. Antigens on RBCs evoke immune responses; antibodies in plasma attack foreign antigens, causing agglutination (clumping).
Transfusion Reaction: Agglutination leads to serious effects (anxiety, pain, hemolysis, jaundice, kidney failure).
Major Antigens: ABO and Rh groups.
ABO Blood Groups
Blood types are determined by the presence or absence of antigens A and B on RBC membranes.
Type A: A antigen, anti-B antibody.
Type B: B antigen, anti-A antibody.
Type AB: A and B antigens, no antibodies (universal recipient).
Type O: No antigens, both antibodies (universal donor).

Agglutination and Transfusion Compatibility
Antibodies react with matching antigens, causing agglutination. Main concern is agglutination of donor RBCs by recipient antibodies.

Universal Donor and Recipient
Universal Recipient: Type AB; can receive any blood type.
Universal Donor: Type O; can donate to any blood type.
Rh Blood Group
The Rh group is based on the presence of antigen D. Rh-positive blood has antigen D; Rh-negative lacks it. Rh-negative individuals develop anti-Rh antibodies after exposure to Rh-positive blood (transfusion or pregnancy).
Erythroblastosis Fetalis: Maternal anti-Rh antibodies attack fetal RBCs in subsequent Rh-positive pregnancies.
Prevention: RhoGAM drug given to Rh-negative mothers during pregnancy.

Summary Table: Blood Composition
Component | Percentage | Main Fun.ction |
|---|---|---|
Plasma | 55% | Transport, regulation, pH maintenance |
Formed Elements | 45% | Oxygen transport, defense, hemostasis |
Red Blood Cells | 95.1% of formed elements | Oxygen and CO2 transport |
White Blood Cells | 0.1% of formed elements | Defense against infection |
Platelets | 4.8% of formed elements | Hemostasis |
Additional info: This summary includes expanded academic context and logical grouping for clarity and completeness